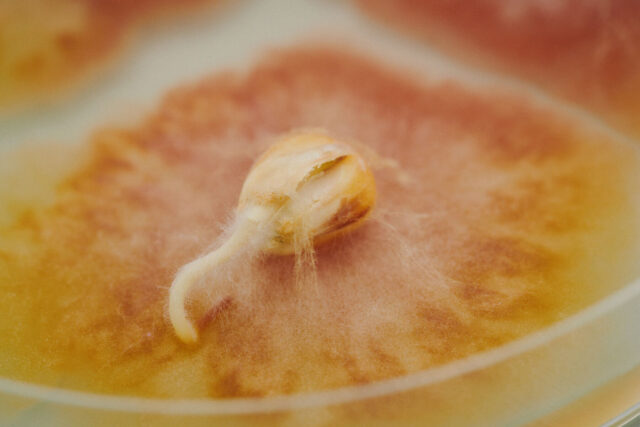

Dr. Harald Keunecke | Principal Scientist Phytopathology Services
Fascinating pathogens:
on the trail of fungal diseases
They decompose organic material, support soil formation and are indispensable for plant growth: Fungi are fascinating life forms and a key component of our ecosystems. However, as phytopathogens, they can also cause huge damage in agriculture. It is estimated that up to 30 percent of the world’s harvests are lost due to fungal infections. It is therefore essential for plant breeding companies to better understand fungi through research.
Higher temperatures, more frequent and more intense precipitation, and weakened plants – in many places, climate change is creating conditions in which pathogens such as viruses, bacteria and especially fungi thrive. At the same time, chemical pesticides are subject to growing restrictions. Developing resistant or tolerant varieties is therefore becoming increasingly important, as is targeted research into the pathogens against which these varieties should be made resistant.
As part of phytopathology at KWS, the working group led by Dr. Harald Keunecke focuses on pathogens that can cause significant yield or quality losses in sugarbeet, oilseed rape, corn, sunflower and cereals. “As phytopathologists, we deal with plant diseases, but the overriding concern is plant health,” says the expert. “The aim is to support breeding and research in developing resistant varieties that exploit their potential even under severe disease pressure.”


Permanent forms of the fungus Sclerotinia sclerotiorum, known as sclerotia.
Crop rotation at risk
White mold is a typical crop rotation disease. The pathogen survives in the form of so-called sclerotia in the soil – resistant, black permanent forms that remain viable for up to ten years. Infected oilseed rape plants show whitish-gray spots with dark edges that develop into a cotton-like mycelium. As a result, the plants ripen prematurely and bend over. Harvesting is then generally no longer possible.
Fungus with a long-term effect
The team is always focused on a host of pathogens, such as the fungus Sclerotinia sclerotiorum, the cause of white mold. The disease poses a major challenge for oilseed rape cultivation, particularly in Central Europe, and so far can only be contained using plant protection products. This is why KWS is researching genetic solutions all the more intensively.
“A core area of our work involves developing test systems that we can use to specifically examine plants under stress conditions,” explains Keunecke. “For white mold, we are working together with our colleagues in oilseed rape breeding to establish a reliable high-throughput test system to identify variety material with increased tolerance. This is an important first step toward robust varieties.”

Leaf spots caused by Cercospora beticola.
Dangerous cycle
Infection of sugarbeet with Cercospora usually begins at the start of July: Spores land on the leaf surface and penetrate the leaf. About two weeks later, the first symptoms appear in the form of small lesions with reddish-brown edges, which later spread to the leaf stalks and merge into one another if the infection is severe. New spore carriers develop in the spots, which in turn release spores – a cycle that endangers entire populations without targeted countermeasures.
Serious leaf spots
While breeding for white mold is still in its infancy, highly effective solutions are already available for other fungal diseases. One particularly important example is the leaf spot disease Cercospora, which is caused by the pathogen Cercospara beticola and is one of the greatest threats to sugarbeet cultivation.
“Cercospora is a global problem,” explains Keunecke, “but it causes particularly severe damage in heavily infested regions such as the United States, Italy, Austria, southern Germany and Japan. Under warm and humid conditions, it can spread explosively.”
The fact that the disease can nevertheless be kept well under control today is primarily down to breeding successes. KWS varieties with innovative CR+ genetics offer high resistance even under high disease pressure. In combination with agronomic measures and the timely use of fungicides, the disease severity can be significantly reduced.
However, there is no room for complacency in breeding and phytopathology at KWS: “Cercospora beticola is a very adaptable fungus. That makes it fas-cinating for us phytopathologists, but all the more threatening for agriculture,” explains Keunecke. “As a plant breeding company, we must always keep an eye on developments in the fields and continuously develop our varieties. It is precisely this momentum that makes our work exciting.”

Fungi of the genus Fusarium cause significant damage to a wide range of crops.

Investment in the future
In order to meet the growing demand for phytopathological research, KWS is establishing a cross-crop phytopathology center at its headquarters in Einbeck. A state-of-the-art facility is being built on an area of about 4,600 square meters, dedicated to research for the global markets.
Our new phytopathology hub in Murcia, Spain, is already in operation – a central hub for phytopathological research into our fruit vegetable crops tomato, cucumber, bell pepper, melon and watermelon. The team’s focus is on finding disease-resistant plant material.


















